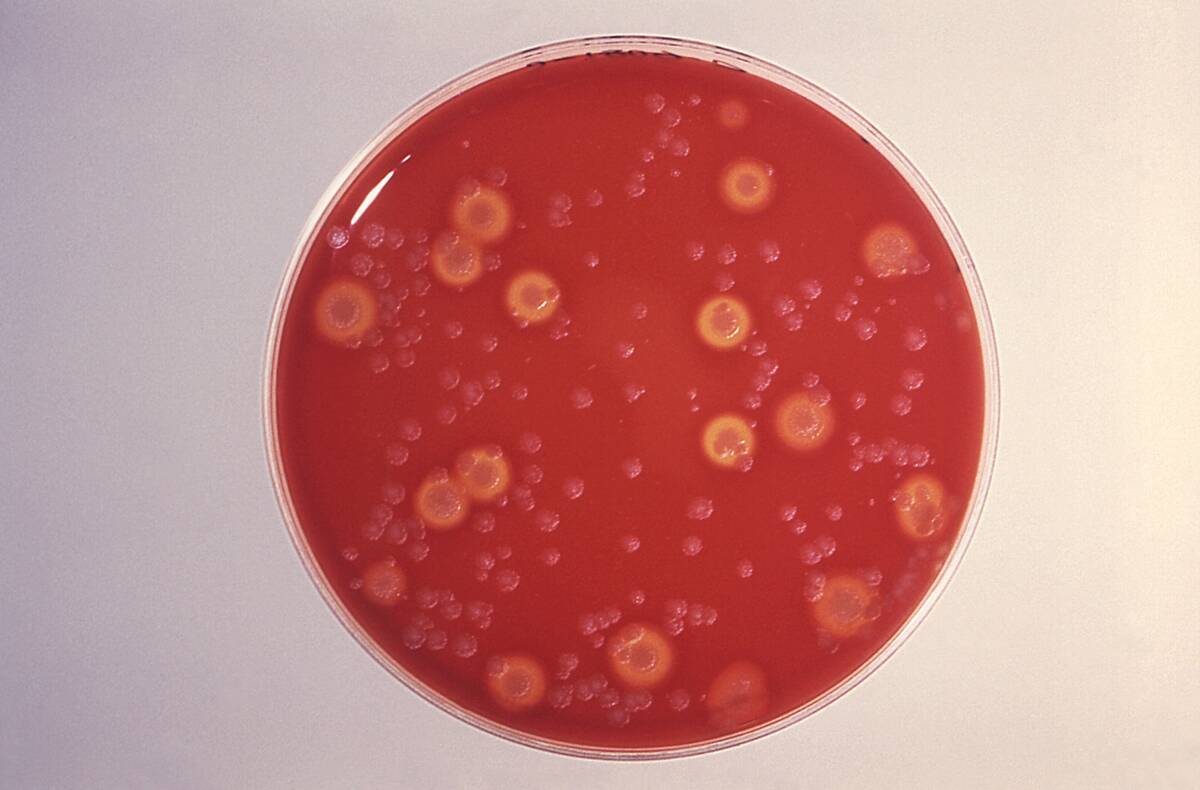
Bacillus Anthracis

What biological weapons are and how they’re used in war
Biological weapons are tools of destruction that exploit living organisms or their toxic products to inflict harm or death on a large scale. Unlike conventional weapons, these agents are invisible to the naked eye, making them particularly insidious. They can be bacteria, viruses, fungi, or toxins.
The use of biological weapons is not just about direct attacks; they can create chaos, disrupt societies, and cause long-term environmental damage. The Geneva Protocol of 1925 attempted to ban their use, but the threat persists.
A Brief History of Warfare: From Swords to Germs

Warfare has evolved dramatically over centuries, transitioning from the clashing of swords to the silent but deadly use of germs. Historically, armies relied on brute force and tactical prowess, but the advent of biological warfare introduced a new dimension to conflict.
This shift began to take shape as early as the 6th century BC when Assyrians reportedly poisoned enemy wells with rye ergot. The potential of biological agents as weapons of war has since loomed large, influencing military strategies worldwide.
The Science Behind Biological Weapons: How They Work

The science of biological weapons revolves around the manipulation of pathogens to maximize their lethality and spread. These agents can be engineered to resist medical treatment or to spread more rapidly among populations. Although such manipulation is more theoretical than not at this point, advanced techniques like CRISPR gene editing make it seem possible in the near future.
Once released, they exploit vulnerabilities in human, animal, or plant hosts, often with devastating consequences. The incubation period of these agents can vary, allowing them to spread unnoticed before symptoms appear, making early detection and response crucial in managing outbreaks.
Nature’s Dark Side: Common Agents Used in Biological Warfare
Biological warfare agents are often derived from naturally occurring pathogens that have been weaponized for maximum impact. Anthrax, caused by the bacterium Bacillus anthracis, is one of the most infamous due to its high mortality rate and resilience.
Smallpox, once eradicated in the wild, poses a threat if used as a weaponized virus. Botulinum toxin, from Clostridium botulinum, is another potent agent capable of causing paralysis. These agents exemplify nature’s dark potential when harnessed for harm.
The Dark Ages: Early Instances of Biological Warfare

Even in ancient times, biological warfare was not unheard of. Historical accounts suggest that during sieges, attackers would catapult plague-infected bodies over city walls to spread disease among the besieged.
The Mongols were notorious for using this tactic in the 14th century at the siege of Caffa, now known as Feodosiya in Ukraine. This early form of biological warfare demonstrated the strategic advantage of disease, long before the science behind pathogens was understood.
Plague and Pestilence: The Middle Ages’ Secret Weapons

The Middle Ages were rife with plagues that decimated populations, and some of these were weaponized by cunning tacticians. During the Hundred Years’ War, rotting animal carcasses were flung over castle walls to spread disease.
The Black Death, a devastating pandemic, was also allegedly used as a weapon by hurling infected corpses into enemy territories. These tactics highlighted the medieval understanding of disease transmission, even if the concept of germs was unknown at the time.
The 20th Century: Modern Warfare Meets Biology

The 20th century marked a turning point where technology and biology intersected in warfare. Nations invested heavily in research to develop biological weapons, recognizing their potential to influence the outcome of conflicts.
The use of chemical weapons in World War I set a precedent, leading to increased interest in biological warfare. Laboratories dedicated to bio-warfare research emerged, resulting in the creation of more sophisticated and deadly agents, raising international concern over the potential for widespread devastation.
World War I: The Silent Strike of Disease

World War I saw the introduction of chemical warfare, but it also set the stage for biological strategies. Although not as prevalent as chemical attacks, biological tactics were considered. The Germans allegedly attempted to infect livestock destined for Allied forces with anthrax and glanders.
This covert operation aimed at undermining the enemy’s food supply highlighted the strategic thinking behind biological warfare. However, the full potential of biological weapons would only be realized in subsequent conflicts.
World War II: The Race for Biological Superiority

World War II intensified the race to develop potent biological weapons. Both the Axis and Allied powers explored the use of pathogens like anthrax and botulism. Japan’s Unit 731 (pictured) infamously conducted experiments on prisoners to test biological weapons, leading to horrific human suffering.
Meanwhile, the United States ramped up its own research, eventually leading to the establishment of the U.S. Army Biological Warfare Laboratories. These efforts underscored the era’s desperate bid for military superiority through science.
The Chilling Cold War: Biological Weapons in the Arms Race

The Cold War era was characterized by a tense arms race, with biological weapons playing a covert role. Both the United States and the Soviet Union invested heavily in biological warfare programs, stockpiling agents like tularemia and anthrax.
The threat of mutually assured destruction loomed large, as each side sought an edge in this deadly game. Despite international treaties, the shadow of biological weapons lingered, contributing to the era’s pervasive atmosphere of distrust and paranoia.
Real-Life Thriller: Infamous Biological Weapon Attacks

Biological weapons have made chilling appearances in real life. The 1984 Rajneeshee bioterror attack in Oregon, where salad bars were contaminated with Salmonella, is a notable example.
In 2001, the United States experienced a series of anthrax attacks through the postal system, causing widespread fear. These incidents reveal the vulnerabilities of modern societies to biological threats and the challenges in tracing and responding to such attacks effectively.
International Law and Biological Weapons: What’s Being Done?

The international community has taken significant steps to curb the threat of biological weapons. The Biological Weapons Convention (BWC), which came into effect in 1975, bans the development, production, and stockpiling of biological and toxin weapons.
Despite its noble goals, the BWC faces challenges due to the lack of a verification regime. Member states work through periodic review conferences to strengthen the treaty, but enforcement remains a complex issue, underscoring the need for continued vigilance and cooperation.
The Role of Biodefense: Protection Against Invisible Enemies

In an era where biological threats loom large, biodefense strategies are crucial for national and global security. These strategies encompass surveillance, detection, and rapid response to biological incidents. Governments invest in research to develop vaccines and treatments, aiming to mitigate the impact of potential outbreaks.
Collaborative efforts between public health institutions and military agencies enhance preparedness. The focus on biodefense reflects a commitment to protecting populations against the invisible enemies of pathogens and toxins.
The Future of Warfare: Are Biological Weapons Here to Stay?

The future of warfare may increasingly involve biological weapons, given advancements in biotechnology and synthetic biology. These fields offer the potential to create novel agents with enhanced capabilities, posing significant challenges to global security.
While international treaties aim to prevent proliferation, the rapid pace of scientific progress demands adaptive strategies. As nations navigate this evolving landscape, the question remains: Will biological weapons become a mainstay of modern warfare, or can diplomacy and innovation steer us toward a more secure future?